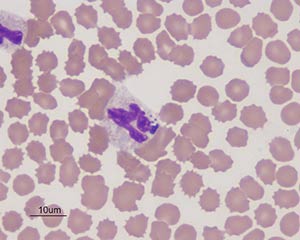

¿Qué es la Piroplasmosis? La piroplasmosis es una enfermedad parasitaria transmitida por una garrapata portadora de un protozoo. A veces es difícil sospechar la enfermedad porque la mayoría de los animales infectados son portadores latentes, que no han mostrado ningún signo clínico sugerente. No es una enfermedad contagiosa y no es transmisible a los …
Archivos del autor:admin
Elementor #5246
¿Como acabar con la cucaracha oriental? Características físicas de la cucaracha oriental La Cucaracha Oriental – Blatta orientalis es una gran especie de cucaracha junto con la cucaracha Americana ya que mide entre 2 y 4 cm de largo cuando es adulta. Es de color marrón oscuro a negro con un cuerpo brillante. Las alas de la …
Peste porcina africana
¿Cómo controlar la peste porcina africana? La peste porcina africana (PPA) es una enfermedad infecciosa de los cerdos causada por un virus de ADN de doble cadena envolvente, el único representante de la familia Asfarviridae y del género Asfivirus. ¿A quién afecta la PPA? La infección de los cerdos domésticos se produce en forma de …
fiebre hemorragica Crimea – Congo
Fiebre hemorrágica de Crimea – Congo Esta enfermedad se describió por primera vez en el decenio de 1940 en la península de Crimea durante una epidemia de fiebres hemorrágicas graves (Chumakov y otros, 1968). El virus se denominó virus de la fiebre hemorrágica de Crimea-Congo (CHFV) tras el aislamiento en 1956 del virus antigénico del …
Encefalitis transmitida por garrapatas
Cómo prevenir la encefalitis transmitida por garrapatas Características del virus de la encefalitis El virus de la encefalitis transmitida por las garrapatas, es el agente etiológico de la encefalitis transmitida por las garrapatas. Las garrapatas adquieren el virus durante las comidas de sangre en un huésped vertebrado en la fase de viremia y lo transmiten a su huésped en …
Bartonelosis
¿Como acabar con la Bartolenosis? Características generales de la Bartolenosis Las bacterias gramnegativas del género Bartonella infectan a muchas especies de mamíferos y algunas de ellas son responsables de enfermedades en humanos y animales. Desde principios de la década de 2000, ha habido muchas pruebas circunstanciales que sugieren que las garrapatas podrían transmitir ciertos …
Tularemia
Tularemia, ¿cómo combatirla? Características de la tularemia La tularemia es una zoonosis que se encuentra casi exclusivamente en el hemisferio norte, causada por la Francisella tularensis, un pequeño coccobacilo aeróbico, gram-negativo, que no es muy resistente a las temperaturas superiores a 0°C en el ambiente externo. Dos subespecies infectan a los seres humanos, la más virulenta biovar tularensis americana y la menos …
Fiebre Q
¿Como erradicar la Fiebre Q? ¿Qué es la fiebre Q? La fiebre Q es una zoonosis en la que el agente causal Coxiella burnetii es una bacteria Gram-negativa intracelular estricta capaz de formar pseudoesporas resistentes en el ambiente externo. Recientemente se han descrito bacterias relacionadas con Coxiella burnetii en muchas especies de garrapatas, bacterias endosimbióticas a priori. Los primeros estudios han …
Anaplasmosis
Anaplasmosis Características generales La familia Anaplasmataceae (orden Rickettsiales) incluye bacterias gramnegativas de los géneros Anaplasma, Ehrlichia, Neorickettsia y Wolbachia, que son organismos intracelulares estrictos, obligados a multiplicarse dentro del citoplasma de las células eucariotas. Entre estas bacterias, nos interesan las de los géneros Anaplasma y Ehrlichia vectorizadas por garrapatas duras. Presentaremos en detalle la anaplasmosis granulocítica debida al Anaplasma phagocytophilum, la más importante en …
Rickettsiosis
Rickettsiosis El género Rickettsia está compuesto por un conjunto de pequeñas bacterias Gram-negativas, parásitos estrictos de las células eucarióticas, y no cultivables en medios inertes. Existe una gran diversidad de especies en este género, la mayoría de las cuales se asocian con artrópodos y actúan como endosimbiontes. Sólo una parte de estas rickettsias están asociadas a las garrapatas, algunas especies …